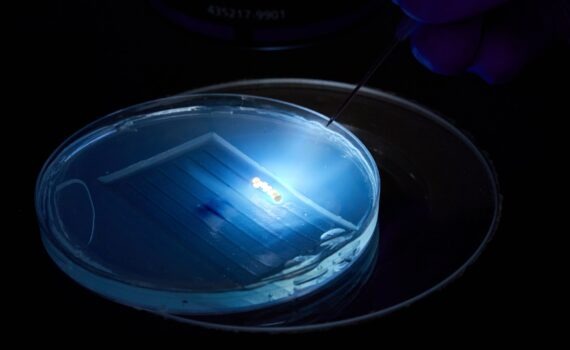

The 2nd Aquaculture Africa Conference (AFRAQ23) took place on 13-16 November 2023 at the majestic Mulungushi International Convention Centre in Lusaka, Zambia. The 2nd Aquaculture Africa Conference (AFRAQ23) took place on 13-16 November 2023 at the majestic Mulungushi International Convention Centre in Lusaka, Zambia. Themed “Resilient value chains in the […]
Daily Archives: 12/15/2023
The world’s seafood leader Thai Union Group has become a signatory to two ambitious global environmental initiatives, Ocean Breakthroughs and Transforming our Food Systems, at the United Nations (UN) Climate Conference in Dubai. For them, this action reinforces the Company’s commitment to sustainable practices and responsible stewardship of the planet’s […]
The United States-Canada operation joint effort with the Japanese developer and proprietary of gene-editing techniques to promote genome editing in major commercial fish species The joint United States-Canada operation Center for Aquaculture Technologies (CAT), leading provider of genetics solutions in aquaculture, announced a collaboration with the Japanese C4U Corporation. Their […]
The global leader in technologically advanced aquatic solutions for aquaculture and fish tracking, Innovasea, recently announced that it has hired Rudi Seim as Managing Director of its office in Bergen, Norway. With more than 15 years of experience in the global aquaculture industry, Seim arrives to Innovasea from Benchmark Genetics, […]
The American National Fisheries Institute (NFI) has announced it will be home to the Global Shrimp Council as the group begins work to create a precompetitive partnership designed to promote United States (US) shrimp consumption. Co-founders David Castro, from Manta Bay Seafood, and Gabriel Luna, from Gluna Shrimp, announced in […]